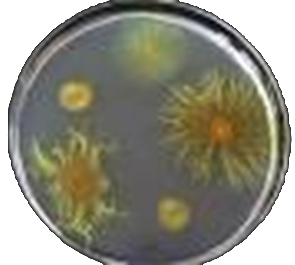

Schulausfall beenden ohne neue Lehrer | Gesundheitstraining Schule
Quelle unsplash Schulausfall verschwindet beim Einsatz vom Verbundenheitstraining auch ohne neue Lehrer. Weil Ursachen von Schulausfall beseitigt werden. Stress, Gewalt, Mobbing, Störungen, Radikalisierungen, Drogen, Kriminalität hören auf. Das Schulklima wird harmonisch. Schüler wie Lehrer sind ausgeglichen und gesund. Schüler entwickeln ihr volles Potenzial und sind bestens auf das Leben vorbereitet.
Schulausfall lässt sich sehr leicht beenden durch Beseitigung von Ursachen. Sind Ursachen weg, verschwinden Symptome.
Neue Lehrer zur Lösung des Problems Schulausfall, wie von Eltern gefordert, sind Symptombekämpfung. Neue Lehrer lösen das Problem Schulausfall nicht nachhaltig. Weil Ursachen von Schulausfall bestehen bleiben.
Das Gesundheitstraining in der Schule geht im Nutzen weit über das hinaus, was mit neuen Lehrern möglich ist. Weil am jeweiligen Schulkonzept nichts geändert werden muss, kann das Gesundheitstraining sofort an allen deutschen Schulen durchgeführt werden. Schulausfall reduziert sich auf ein Minimum in ganz Deutschland. Ohne neue Lehrer- mit relativ wenig finanziellem Aufwand. Für die Erprobung des Konzeptes suche ich, Volker Schmidt, aktuell eine Schule im deutschen Bundesgebiet (Stand November 2017).
Innovatives Konzept zur Lösung des Problems Schulausfall
Schulausfall durch Krankheit verschwindet im Europamodell durch Beseitigung von Ursachen. Damit Lehrer wie Schüler nicht mehr krank werden, gehen Verbundenheitstrainer an Schulen und führen das Verbundenheitstraining durch. Hauptinstrument ist die AG Potenzialentfaltung und ein spezielles Training für Lehrer. Die enge Einbindung der Eltern in die gemeinsame Arbeit vervollständigt das innovative Konzept.
Die Innovation am Verbundenheitstraining ist, dass Schüler und Lehrer befähigt werden, gemeinsam Wohlbefinden herzustellen- ohne Therapie, suggestive Beeinflussung oder Bevormundung.
Der Weg zu Wohlbefinden (körperlich, seelisch, sozial) ist in jedem Menschen angelegt. Verbundenheitstraining hilft, diesen Weg eigenverantwortlich zu finden und zu beschreiten.
Damit Schüler, Lehrer, Eltern völlig eigenverantwortlich Wohlbefinden herstellen können, erhalten sie Werkzeuge und einen geschützten Raum, um Veränderungen im innen eigenverantwortlich durchführen zu können. Im Gesundheitstraining Schule gibt es keinen Arzt, Therapeut oder Sozialarbeiter, der herum therapiert.
Durch die Beseitigung von Ursachen entsteht mehr Miteinander. Das führt zu mehr körperlichem, seelischem und sozialem Wohlbefinden aller Beteiligten.
Das Training für Schüler, Lehrer und Eltern erfolgt als Hilfe zur Selbsthilfe.
Mit der Hilfe zur Selbsthilfe des Verbundenheitstrainings für Lehrer, Schüler und Eltern wird im Europamodell das Problem Schulausfall an der Ursache gelöst. Weil Schüler und Lehrer durch eigenverantwortliche Hintergrundaufarbeitung gesund bleiben.
Viele Probleme an Schulen wie Gewalt, Mobbing, Störungen, Radikalisierungen, Drogen, Kriminalität verschwinden quasi als Nebenprodukt.

Nutzen Gesundheitstraining Schule
Krieg an Schulen- neue Lehrer lösen das Problem Schulausfall nicht
An deutschen Schulen herrscht Krieg. Um Schulausfall zu beenden, muss im ersten Schritt der Krieg beendet werden.
Neue Lehrer an Schulen schicken ist so, wie wenn Adolf Hitler frische Kräfte an die Ostfront schickt, um dort den Krieg zu gewinnen.
Um das Problem Schulausfall zu lösen, muss zuerst der Krieg an Schulen aufhören. Ist der Krieg an Schulen zu Ende, werden auch keine Lehrer mehr an deutschen Schulen verschlissen.
Negativer Dauerstress ist Ursache nahezu aller Krankheiten und somit Ursache für Schulausfall durch Krankheit. Damit Schulausfall durch Krankheit beendet wird, muss negativer Dauerstress- Folge des Krieges- aufhören.
Nicht neue Lehrer, sondern das Gesundheitstraining in Kindergarten und Schule löst das Problem Unterrichtsausfall. Weil Ursachen von Schulausfall beseitigt werden.
Soll Schulausfall beendet werden, muss Krankheit beendet werden. Weil Lehrer und Schüler durch das Gesundheitstraining der Schule im Europamodell kaum noch krank sind, löst sich das Problem Schulausfall in Luft auf.
Einstellung neuer Lehrer ist Symptombekämpfung. Mit neuen Lehrern wird Schulausfall nicht reduziert. Mögliche Anfangseffekte sind nur vorübergehend, weil Ursachen in Struktur und Umgebung nicht beseitigt werden. Anfangseffekte beruhen auf der Unverbrauchtheit junger Lehrer. Weil Schule aber auf Verschleiss fährt, sind junge Lehrer nach kurzer Zeit auch verschlissen und werden krank. Besser ist es dafür zu sorgen, dass Lehrer nicht krank oder arbeitsunfähig werden. Dieses Ziel wird erreicht mit dem Gesundheitstraining für Schüler, Lehrer und Eltern im Europamodell.
Schulausfall Ursache Nr. 1- negativer Dauerstress
Schulausfall Ursache Nr. 1 ist negativer Dauerstress bei Lehrern und Schülern.
Damit Schulausfall verschwindet, sind nicht neue Lehrer an Schulen die Lösung, sondern die Beseitigung der Ursachen vom Stress. Ursachen vom Stress sind aktive Konflikte/ Probleme, unerfüllte Hoffnungen, Wünsche, Bedürfnisse, seelische Not bei Lehrern wie Schülern. Verschwindet seelische Not und alle Akteure fühlen sich wohl in der Schule, verschwindet auch Schulausfall.
Verändert sich das Klima an Schulen von Gegeneinander zu Miteinander, hört negativer Stress bei Schülern und Lehrern auf. Weil Schule positive Signale aussendet und Seelen von Schülern wie Lehrern in Harmonie sind, entsteht stabiles Wohlbefinden. Schüler wie Lehrer werden kaum noch krank. Schüler entfalten ihr volles Potenzial.
In die AG Potenzialentfaltung gehen Schüler, die mehr Wohlbefinden haben und ihr eigenes Potenzial voll entfalten wollen.
Es findet zunächst gesundheitliche und beziehungstechnische Wissensvermittlung statt. Praktisch erforschen Schüler ihre Innenwelt und lernen die immensen Möglichkeiten der eigenverantwortlichen Nutzung kennen.
Schüler üben durch praktisches Handeln in ihrer eigenen Innenwelt aktiv Konflikte/ Probleme zu lösen, erforschen Wege zur Erfüllung eigener Hoffnungen, Wünsche, Bedürfnisse.
Schüler und Lehrer lernen, die eigene Innenwelt zu nutzen, um Antworten auf aktuelle Fragen zu bekommen. Innenwelt ist Zugang zu universellem Wissen.
Für Lehrer gibt es ähnliche Angebote. Auch Lehrer werden in der praktischen Nutzung der eigenen Innenwelt ausgebildet, damit sie selber aktiv Wohlbefinden herstellen können. Lehrer und Schüler arbeiten getrennt.
Eltern bekommen an Elternabenden vermittelt, was ihre Kinder in der AG Potenzialentfaltung machen. Schüler, Lehrer und Eltern bilden ein Team mit dem Ziel, dass sich alle wohl fühlen und optimal entfalten.
Ziel der AG Potenzialentfaltung
Ziel der AG Potenzialentfaltung ist, das jedem Schüler inne liegende Potenzial voll zu entfalten.
Schüler sollen einen geschützten Raum bekommen, wo sie neue Dinge ausprobieren und eigene versteckte Potenziale entdecken können. Das geht am einfachsten und am effektivsten in der Innenwelt. Durch innere und äußere Änderungen kommen die Schüler dann ins Reine mit sich selber und ihrer Umgebung.
Durch die innere Arbeit sollen sich gesundheitsfördernde Automatismen im Unterbewusstsein bilden, die ein Leben lang positiv wirken. Es sammelt sich wenig Seelenmüll an, der im späteren Leben für ernsthafte Probleme (mit sich selbst, Beziehungen, Beruf, Gesundheit) sorgen könnte.
Durch die AG Potenzialentfaltung werden Schüler fähig, durch Eigenaktivität Wohlbefinden, Sinnerfüllung, Sicherheit und Freude herzustellen. Das ist der mit Abstand wichtigste Gesundheitsfaktor Selbstregulation. Je besser die Selbstregulation, je kleiner ist die Gefahr zu erkranken.
Weil durch die AG Potenzialentfaltung zwischenmenschliche Konflikte verschwinden, gehen Schüler gern in die Schule gehen, weil sie dort viele Freunde haben. Auch die Freude am lernen bleibt erhalten.
Weil durch mehr Miteinander zwischenmenschlicher Stress verschwindet, sind Kinder sowie Jugendliche aufnahmefähiger, leistungsfähiger, gesünder. Diese Zusammenhänge haben Gehirnforschung und Epigenetik bewiesen. Schulausfall durch Krankheit bei Lehrern und Schülern verschwindet.

Positives Schulklima und stressfreie Seelen bei Schülern und Lehrern sorgen für Wohlbefinden. Schulausfall verschwindet.
Das Problem Schulausfall wird nicht gelöst durch neue Lehrer. Neue Lehrer sind Symptombekämpfung. Neue Lehrer werden genauso krank wie alte Lehrer, weil die Ursachen von Unterrichtsausfall nicht beseitigt werden.
Ursachen von Unterrichtsausfall
Ist ein Lehrer krank, fällt Unterricht aus. Schüler verpassen Unterrichtsstoff.
Wie Krankheit entsteht, erforscht der Wissenschaftszweig der Epigenetik. Epigenetik beschreibt, wie Signale der Umgebung über Gehirn und Anschaltung von Genen sämtliche körperliche Vorgänge auslösen. Über die An- Abschaltung von Genen entsteht Gesundheit oder Krankheit. Das ist eine wissenschaftliche Tatsache.
Schulausfall durch Krankheit entsteht in der Hauptsache durch 2 Faktoren:
1. Signale der Umgebung
2. Seele des Betreffenden.
Signale der Umgebung Schule stehen in Wechselwirkung mit der Seele von Lehrern und Schülern. Für die Auslösung körperlicher Vorgänge (Gesundheit, Krankheit) sind dann Mechanismen der Wahrnehmung verantwortlich.
Wahrnehmung ist Schalter der Gene. Je nachdem, welche Gene durch das Gehirn angeschaltet oder abgeschaltet werden, entstehen körperliche Vorgänge. Die Regulation der Genaktivität ist ein perfektes System, welches sich im Laufe der Evolution gebildet hat.
Über die Genregulation wird seelische Not von Lehrern und Schülern als Krankheit sichtbar. Ist seelische Not zu groß, folgt die Flucht in Krankheit. Krankheit verschafft eine Auszeit vom Stress der Schule. Zu Hause kann sich der leere Akku wieder aufladen und körperliche Vorgänge normalisieren.
Soll Gesundheit bei Lehrern und Schülern entstehen, um Schulausfall auf ein Minimum zu reduzieren, muss sich das Klima an Schulen verändern. Damit Signale in Schulklassen positiv sind und Schüler sowie Lehrer nicht mehr krank werden.
Damit sich das Klima an Schulen zum Positiven ändert, gehen im Europamodell Synergetik Lehrer in Kindergärten und Schulen. Dort führen sie ein hoch innovatives Gesundheitstraining durch.
Gesundheitsfördernde Automatismen möglichst früh bilden
Die Fähigkeit, durch Eigenaktivität Gesundheit herzustellen, entwickelt sich in der frühesten Kindheit.
In der Kindheit entstehen Automatismen, die ein Leben lang wirken. Damit Kinder und spätere Erwachsene bis ins hohe Alter ausgeglichen und gesund sind, gibt es im Europamodell ein Gesundheitstraining in Kindergarten und Schule. Kindergarten deshalb, damit sich gesundheitsfördernde Automatismen möglichst früh bilden. Es schafft Bedingungen, damit sich Kinder und Jugendliche gemäß ihren Voraussetzungen optimal entwickeln.
Um den mit Abstand wichtigsten Gesundheitsfaktor Selbstregulation stetig zu verbessern, lösen Kindergartenkinder und Jugendliche unter Anleitung von Synergetik Lehrern in Eigenregie gemeinsam Konflikte/ Probleme, erfüllen sich selber Hoffnungen, Wünsche, Bedürfnisse und üben Eigenverantwortung.
Kinder und Jugendliche unterstützen sich gegenseitig, damit sich alle in der Schule wohl fühlen. Sind Kinder durch das Gesundheitstraining im Reinen mit sich und ihrer Umgebung, werden sie traurig, können sie einmal nicht den Tag mit ihren Freunden in Kindergarten oder Schule verbringen.
Synergieeffekte
Das Gesundheitstraining in Kindergarten und Schule bewirkt kurz- wie langfristig die größten Synergieeffekte im neuen Gesundheitssystem Europamodell. Daher ist der Einsatz des Verbundenheitstrainings in Kindergarten und Schule die mit Abstand wichtigste Maßnahme gesellschaftlicher Veränderungen im Europamodell. Das Gesundheitstraining in der Schule steht für mich in einer Rangliste noch über der Heilung durch Selbstheilung schlimmster Krankheiten wie Krebs, ALS, MS usw. Weil nahezu alle Krankheiten mit wenig Aufwand frühzeitig vermieden werden können.
Störenfriede und Egoisten
Gibt es Störenfriede oder Egoisten an Schulen, welche pardout den Unterricht stören oder andere Kinder hänseln wollen, so können sie es gern weiter versuchen. Je stärker aber die Gruppe der Schüler wird, die ein friedliches Miteinander wünscht und lebt, je schwächer wird der Einfluss der Störenfriede. Der positive Ordnungsparameter Miteinander entsteht in der AG Potenzialentfaltung.
Im Leben gibt es immer jemand, der etwas macht und jemand, der etwas mit sich machen lässt. In der AG Potenzialentfaltung üben Schüler, für sich selber einzustehen. Ist diese Fähigkeit stark genug, lassen Schüler nicht mehr alles mit sich machen. Kinder mit starkem Selbstbewusstsein treten selbstbewusst für sich selber und andere ein.
Nutzen vom Gesundheitstraining für Kinder, Jugendliche, Eltern, Lehrer
Schulausfall sinkt, weil sich das Klima an Schulen dramatisch von Egoismus in Richtung Miteinander ändert. Sendet die Umgebung positive Signale, bewirkt die Genregulation stabile Gesundheit. Durch mehr Wohlbefinden sind Kinder, Jugendliche und Lehrer kaum noch krank.
Für die Lösung der Probleme und die Verbesserung des Schulklimas gehen Synergetik Lehrer in Schule und Kindergarten. Kindergarten deshalb, damit Kinder möglichst früh gesundheitsfördernde Automatismen üben. Es soll sich möglichst wenig Seelenmüll im Unterbewusstsein der Kinder ansammeln. Grundlage des Gesundheitstrainings in der Schule ist das Verbundenheitstraining.
Schüler entwickeln ihr volles Potenzial, sind aufnahmefähiger, bleiben gesund und gehen gern in die Schule.
Weil Kinder ausgeglichen, im Reinen mit sich selber und ihrer Umgebung sind, werden Mobbing, Überforderung, ADHS, sonstige Symptome, Amok, Radikalisierung, Kriminalität, Drogenkonsum auf ein Minimum reduziert oder verschwinden.
Gewalt gegen Lehrer, Berufsunfähigkeit oder Bournout werden durch das positive Klima an Schulen vermieden. Unterstützend wirkt der rege Austausch von Schülern, Eltern, Lehrern, Schulleitung und Jugendamt.
Auch Eltern haben einen hohen Nutzen.
Mutter wie Vater wollen, dass das eigene Kind gern in die Schule geht und optimal auf das Leben vorbereitet wird. Das passiert durch das Gesundheitstraining in Kindergarten und Schule. Schüler entwickeln Fähigkeiten, die ihnen ein Leben lang helfen werden, zufrieden, ausgeglichen, gesund, in Harmonie mit sich selber und der Lebensumgebung zu sein.
Übernahme von Eigenverantwortung, die Fähigkeit Konflikte/ Probleme zeitnah zu lösen und sich eigene Hoffnungen, Wünsche, Bedürfnisse erfüllen zu können, ist sehr wichtig im Leben.
Aufmerksamkeit, Konzentration und Lernfähigkeit der Schüler werden besser
Negativer Dauerstress, aktiviert durch Signale einer negativen Umgebung wie dem Krieg in Schulen, vermindert Aufmerksamkeit, Konzentration und Lernfähigkeit der Schüler. Verschwindet negativer Stress, werden Aufmerksamkeit, Konzentration und Lernfähigkeit der Schüler besser.
Grund für eine verminderte Aufmerksamkeit, Konzentration und Lernfähigkeit ist folgender:
Negativer Stress wie Schulstress aktiviert die Stressachse. Die Stressachse ist ein Überlebensprogramm der Evolution, welche seit Menschen Gedenken das Überleben eines Individuums sichert.
Kommt der Löwe, muss man weg, kämpfen oder sich tot stellen. Damit genug Energie zur Verfügung steht, geht Energie von Organen mit Wachstumsfunktion (z.B. Verdauung, Immunsystem) in Organe mit Schutzfunktion (Arme, Beine).
Um weg zu laufen oder zu kämpfen, bracht man auch keine gedanklichen Höchstleistungen. Denn es geht ums nackte Überleben.
Das evolutionäre Programm ist Grund, warum Schüler bei negativem Stress (Konflikte, Mobbing, Überforderung) schlechter lernen. Es steht ganz einfach weniger Energie für Aufmerksamkeit, Konzentration und Lernfähigkeit zur Verfügung.
In der AG Potenzialentfaltungüben Schüler unter Anleitung ihrer Synergetik Lehrer gemeinsam offene Kommunikation. Sie lösen gemeinsam Konflikte/ Probleme und üben, durch Eigenaktivität sich eigene Hoffnungen, Wünsche, Bedürfnisse zu erfüllen. Durch die gemeinsame Arbeit verschwindet Trennendes und es entsteht ein Wir-Gefühl der Verbundenheit und des Miteinanders.
Da alle Kinder und Jugendlichen am Gesundheitstraining teilnehmen, ändert sich das Klima an Schulen von Gegeneinander zu Miteinander. Kinder und Jugendliche gehen gern in die Schule, weil sie sich dort wohl fühlen.
Weil negativer Stress bei den Schülern verschwindet, werden Aufmerksamkeit, Konzentration und Lernfähigkeit besser. Unterrichtsstoff wird besser aufgenommen. Die Schüler bringen bessere schulische Leistungen. Ohne büffeln oder stures auswendig lernen. Freude ist Dünger für das Gehirn.
Signale der Umgebung- wie Schule gesund oder krank macht
Zellen in einer nährstoffreichen Umgebung.
Zellkulturen wachsen und gedeihen optimal.
Auch Kinder und Jugendliche entwickeln sich optimal,
wird in Kindergarten und Schule das Gesundheitstraining eingesetzt.
Folgenden Versuchsaufbau kennt jeder Biologe. Der Versuch zeigt, welchen Einfluss die Umgebung auf Menschen hat. Positive Umgebungen fördern Gesundheit- negative Umgebungen machen krank. Ist jemand negativen Signalen der Umgebung zu lange ausgesetzt, kann das auch den Tod des Individuums nach sich ziehen. Die entsprechenden köperlichen Vorgänge löst das Gehirn über die Genregulation aus. Signale der Umgebung sind Auslöser für Krankheit und Schulausfall. Ursache ist die Seele, die sich schützen und weiterentwickeln will.
In eine Schale gibt man lebende Zellen in verschiedene Umgebungen. Anschließend kann man beobachten, was passiert.
Zellkulturen in positiven Umgebungen (Nährstoffreich, liebevolle Umgebung etc.) wachsen und gedeihen.
Sind Zellen negativen Umgebungen (Umweltgifte, Mobbing, Überforderung, lieblose Umgebung etc.) ausgesetzt, kümmern sie vor sich hin oder sterben.
Das Prinzip „Signale der Umgebung aktivieren körperliche Vorgänge“ greift bei Kindern, Jugendlichen, Eltern und Lehrern gleichermaßen. Damit Kinder sowie Jugendliche wachsen, gedeihen und sich optimal entfalten, ist ein Ziel des Gesundheitstrainings in der Schule, eine Umgebung herzustellen, wo sich alle Beteiligten wohl fühlen. Damit Probleme in Schule, Kindergarten und Familie gelöst werden, muss die Umgebung positive Signale aussenden.
Die Hilfe zur Selbsthilfe der Synergetik Lehrer im Europamodell hilft dabei, die Umgebung Kindergarten, Schule und Elternhaus positiv zu verändern. Daran haben Schüler, Eltern, Lehrer und Gesellschaft ein gemeinsames Interesse.
Familie ist in das Gesundheitstraining der Schule integriert, weil Kinder ungelöste Konflikte/ Probleme von zu Hause in den Schulalltag mitnehmen und im Elternhaus unterdrückte Gefühle gegen andere Schüler oder Lehrer ausleben. Sind Konflikte/ Probleme in Familien gelöst, ist auch im Klassenzimmer Ruhe.
Ergänzung AG Potenzialentfaltung durch Fach Gesundheit
Um das Gesundheitstraining in Kindergarten und Schule zu integrieren, braucht es Strukturen. Diese Strukturen schafft die AG Potenzialentfaltung.
Ergänzen kann die AG Potenzialentfaltung noch ein Fach Gesundheit. Das würde aber gesetzgeberische Konsequenzen haben. Gesundheitliche Inhalte können alternativ auch in Biologie integriert werden.
In der AG Potenzialentfaltung arbeiten Kinder und Jugendliche, welche die immensen Möglichkeiten innerer Reisen für sich erschließen und praktisch miteinander arbeiten wollen.
An der AG Potenzialentfaltung können zum Beispiel Schüler teilnehmen, welche gesundheitliche Probleme oder wenig Selbstbewusstsein haben, gemobbt werden oder die immensen Möglichkeiten der eigenen Innenwelt für sich selber erschließen wollen. In der Innenwelt entsteht alles: Ideen, Konzepte, Pläne, Haltungen, körperliche Vorgänge.
Die praktische Nutzung der Innenwelt ist die Zukunft. Vergleichbar mit dem Potenzial des Internet.
Werden Kinder und Jugendliche in der AG Potenzialentfaltung durch die inneren Reisen innerlich gestärkt, entsteht ein neuer positiver Ordnungsparameter in Klassen. Schüler, die bisher andere Schüler tyrannisierten oder den Unterricht störten, haben immer weniger Einfluss. Das Klima in Klassen wird harmonischer und ändert sich in Richtung Miteinander.
Im Fach Gesundheit (Alternative Integration in Biologie) wird Schülern das theoretische Wissen vermittelt.
Lehrer können zudem mit allen Schülern aktiv Konflikte/ Probleme lösen, Schüler ermutigen, eigene Hoffnungen, Wünsche, Bedürfnisse zu kommunizieren und auf diesem Weg Wohlbefinden (Körper, Seele, Sozial) in Klassen herzustellen. Im Grunde die selbe Arbeit wie in der AG Potenzialentfaltung.
Ein Fach Gesundheit ist wichtig, damit alle Schüler und Jugendlichen in den Genuss des Verbundenheitstrainings kommen. Denn die AG Potenzialentfaltung ist freiwillig. Dass alle Schüler in den Genuss des Verbundenheitstrainings kommen, hat große gesellschaftliche Relevanz.
In entsprechenden Techniken werden Fachlehrer zuvor von den Synergetik Lehrern ausgebildet.
Ziel ist, dass sich Synergetik Lehrer immer mehr aus dem Schulalltag heraus nehmen, damit die Klasse aus sich heraus für Wohlbefinden und positive Signale sorgt. Das passiert dann über Selbstorganisation.
Welche Methodik zum Einsatz kommt, wird zuvor mit Bildungsministerium, Schulamt, Schulleitung und Eltern abgesprochen.
Das Problem Unterrichtsausfall beginnt in Bildungsministerien
Anmerkung Volker Schmidt: 
Zitat Thüringer Bildungsminister Matschie in der Thüringer Allgemeine vom 10.April 2013:
… Seit meinem Amtsantritt habe ich deshalb begonnen,
Schritt für Schritt jedes Jahr mehr junge Lehrer einzustellen.
Denn das ist die beste Medizin gegen Schulausfall.
Die Hypothese des Herrn Matschie ist Wissenschaftlich in keinster Weise zu belegen
und kostet dem Steuerzahler viel Geld.
Das Problem Unterrichtsausfall beginnt nicht in Schulen, sondern in Bildungsministerien. Weil z.B. in Thüringen Politiker wie Ex-Bildungsminister Matschie (SPD) auf falsche Lösungsstrategien setzen.
Solange Politiker wie der Thüringer Ex-Bildungsminister Matschie in der Presse lauthals verkünden, „die beste Medizin gegen Schulausfall sind neue Lehrer“, ändert sich an deutschen Schulen nichts. In Bildungsministerien beginnen die Probleme an Schulen.
Politiker wie Herr Matschie (SPD) richten mehr Schaden an, als dass sie positive Veränderungen in Gang setzen. Denn falsche Lösungsstrategien kosten Steuer- und Beitragszahler viel Geld.
Unter Politikern scheint die Haltung „nach mir die Sintflut“ offenbar weit verbreitet zu sein. So lange Politiker und hohen Regierungsbeamte in der Entwicklungsverweigerung stecken und nur um Posten buhlen, wird sich auch an Zuständen in deutschen Schulen nichts ändern.
Politiker und Regierungsbeamte in Thüringer Ministerien sind ganz offensichtlich lernresistent. Statt das Gesundheitstraining in der Schule zu testen, wie in der Petition 2016 „Seelische Heilung im Gesundheitssystem- Europamodell“ erbeten, setzt die Thüringer Regierungskoalition unter Rot-Rot-Grün weiter auf völlig ungeeignete Problemlösungsstrategien.
Zum Nachteil für Schüler, Lehrer, Eltern, das Land Thüringen und die BRD. Denn das Know-how des Gesundheitstrainings soll nach erfolgreicher Erprobung in allen Schulen Deutschlands zugänglich sein.
Thüringen setzt weiter auf die längst überholte Symptom-Bekämpfung-Strategie neue Lehrer.
Wie Schulmediziner mit ihrem „Kampf gegen Symptome“.
Weiter: Bericht „Zukunft Schule“: Thüringen will Lehrer mit Gehaltszulagen locken
Bundesland für Erprobung des Gesundheitstrainings in der Schule gesucht
Im Thüringer Bildungsministerium scheint es an wichtigen Positionen nur Entwicklungsverweigerer zu geben, die an einer ursächlichen Lösung der Probleme an Schulen keinerlei Interesse haben. Einzige Problemlösungsstrategie scheint Verbeamtung und Einstellung neuer Lehrer zu sein.
Dieses Vorgehen ist völliger Unsinn und teuer.
Im meiner Petition zum Europamodell im Jahr 2016 bat ich um Erprobung des Gesundheitstrainings in der Schule.
Nach erfolgreicher Erprobung sollte das Training flächendeckend in ganz Deutschland eingesetzt werden. Daran hat aber das Bundesland Thüringen keinerlei Interesse.
Wenn Sie als Verantwortlicher im Bildungsministerium eines anderen Bundeslandes als Thüringen Verantwortung tragen, können wir in Ihrem Bundesland gern das Gesundheitstraining in der Schule austesten. Kontaktieren Sie mich.
Schüler und Eltern, also Ihre Wähler, werden es Ihnen danken.
Mehr Infos
http://www.verbundenheitstraining.de/staat/schule_im_europamodell.htm

